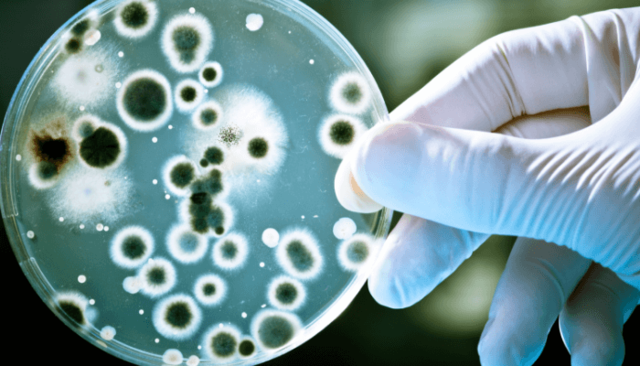
PENICILINA

-
Tales de Mileto se le otorga el descubrimiento de un mineral que tenía la propiedad de atraer ciertos metales: la magnetita. Tales observaría que frotando hierro a la magnetita, éste adquiría las propiedades magnéticas.
-
Aristóteles sostuvo un sistema geocéntrico, en el cual la Tierra se encontraba inmóvil en el centro mientras a su alrededor giraba el Sol con otros planetas.
-
Fundamentos en hidrostática, estática y la explicación del principio de la palanca. Es reconocido por haber diseñado innovadoras máquinas, incluyendo armas de asedio y el tornillo de Arquímedes.
-
Andrés Vesalio disecciona cadáveres humanos, revelando información de la anatomía humana y cree que su comprención es crucial para la realización de cirugías.
-
Nicolás Copérnico coloca al sol y no la Tierra, en el centro del sistema solar.
-
Fue propuesta por Nicolás Copérnico, la teoría heliocéntrica sostiene que la Tierra y los demás planetas giran alrededor del Sol.
-
*Los planetas tienen movimientos elípticos alrededor del Sol, estando éste situado en uno de los 2 focos que contiene la elipse.
*Las áreas barridas por los radios de los planetas son proporcionales al tiempo empleado por estos en recorrer el perímetro de dichas áreas.
*El cuadrado de los períodos de la órbita de los planetas es proporcional al cubo de la distancia promedio al Sol -
Galileo Galilei vuelca casi 2.000 años de creencia aristotélica de que los cuerpos más pesados caen más rápido que los livianos, demostrando que todos los cuerpos caen a la misma velocidad.
-
Johannes Kepler elabora las leyes que son eficientes para predecir los movimientos de los planetas en órbitas elípticas.
-
William Harvey descubre que la sangre circula por el cuerpo y su ensayo anatómico sobre el movimiento del corazón y la sangre en los animales sienta las bases de la fisiología moderna.
-
Isaac Newton llega a la conclusión de que todos los objetos del universo ejercen una atracción gravitatoria sobre los demás.
-
El descubrimiento del plomo en partículas subatómicas da como conclusión que las interacciones en el universo son el resultado de cuatro fuerzas (nucleares fuertes y débiles, electromagnética y la gravedad).
-
Con un microscopio de lente de molino, Anton Van Leeuwenhoek descubre accidentalmente los microorganismos en una gota de agua. Sus observaciones sentaron las bases de las ciencias de la bacteriología y microbiología.
-
Isaac Newton cambia nuestra comprensión del universo mediante la formulación de tres leyes que describen el movimiento de los objetos.
-
Newton utiliza un prisma para dividir la luz blanca en sus colores constituyentes y otro prisma para mezclar los colores en la luz blanca. Einstein reconoce que la luz siempre viaja a una velocidad constante.
-
Edmund Halley sugiere que los cometas orbitan alrededor del Sol y predice el regreso del Cometa Halley, esta predicción se demostró en 1758 cuando vuelve el cometa.
-
Carlos Linneo "padre de la taxonomía" desarrolló un sistema para clasificar las formas de vida, el sistema utiliza una jerarquía dividiéndolos en clases, órdenes, familias, géneros y especies.
-
Joseph Priestley descubre el oxígeno, más tarde, produce el oxígeno en experimentos, describe su papel en la combustión y la respiración, ajeno la importancia de su descubrimiento. Lavoisier describe correctamente su función en la combustión.
-
Jan Ingenhousz descubre que las plantas reaccionan a la luz solar de manera diferente y forma las bases de la fotosíntesis; proceso en el cual las plantas y algunas bacterias convierten la energía de la luz en energía química.
-
William Herschel realizo un mapa del cielo para demostrar que nuestro sistema solar se encuentra en un disco de estrellas (Vía Láctea).
-
Edward Jenner, un médico rural Inglés, realiza la primera vacunación contra la viruela después de descubrir que la inoculación con viruela proporciona una inmunidad.
-
El químico francés Louis Pasteur descubre que ciertos microbios son agentes causantes de enfermedades debido a eso se llama el "padre de la bacteriología".
-
El físico danés Hans Christian Oersted al hablar con los estudiantes sobre la posibilidad de que la electricidad y el magnetismo están relacionados, durante la conferencia, un experimento demuestra la veracidad de su teoría frente a toda la clase.
-
Humphry Davy encuentra que la electricidad transforma productos químicos.Con baterías es capaz de separar el potasio y el sodio elemental en el calcio, estroncio, bario y magnesio.
-
Amedeo Avogadro descubre que los átomos de los elementos se combinan para formar moléculas. Propone que volúmenes iguales de gases en igualdad de condiciones contienen el mismo número de moléculas.
-
William Buckland descubre dientes muy grandes en Inglaterra en ese momento, no hay palabra para su descubrimiento. Sir Richard Owen viene con la palabra "dinosaurio" para referirse a varias criaturas cuyos fósiles se descubrieron en Inglaterra. Megalosaurus es el primer nombre de dinosaurio.
-
Robert Brown identifica una estructura dentro de las células que él llama el "núcleo".
-
Se descubre que ciertas sustancias químicas pueden ser utilizadas como anestésico, los primeros experimentos con agentes anestésicos fueron con óxido nitroso (gas hilarante) y éter sulfúrico.
-
Gregor Mendel descubre cómo la información genética se transmite de generación en generación. En experimentos llevados a cabo en las plantas de guisantes, se da cuenta de las características de la descendencia de la planta.
-
Charles Darwin publica "El Origen de las Especies Mediante la Selección Natural", en la que desafía las creencias acerca de la creación de la vida en la Tierra.
-
Dmitry Mendeleyev se da cuenta de que si todos los 63 elementos conocidos están dispuestos en orden de mayor peso atómico, sus propiedades se repiten de acuerdo a ciertos ciclos periódicos.
-
John Wesley Hyatt crea el plástico celuloide para su uso como sustituto de marfil en la fabricación de bolas de billar.
-
August Weismann identificó que las células sexuales se dividen de manera diferente y pueden terminar con la mitad de un conjunto de cromosomas (meiosis). Realizó experimentos con medusas lo que le dio la conclusión de que las variaciones son el resultado de la descendencia de la unión de los padres (plasma germinal).
-
Marie y Pierre Curie descubren y aíslan los materiales radiactivos. Después de la extracción de uranio químicamente a partir del mineral de uranio, Marie toma nota de los materiales residuales es más "activa" que el uranio puro.
-
Wilhelm Roentgen descubre accidentalmente los rayos X al realizar experimentos con la radiación de rayos catódicos (electrones). Gracias a su descubrimiento se le otorgó el primer Premio Nobel de Física en 1901.
-
J.J Thomson descubre que las partículas con carga negativa emitida por los tubos de rayos catódicos son más pequeñas que los átomos. Estas partículas son conocidas ahora como electrones.
-
Frederick Hopkins descubre que las enfermedades son causadas por la deficiencia de nutrientes (vitaminas). A través de experimentos de alimentación con animales llega a la conclusión de que estos factores alimenticios son esenciales para la salud.
-
Para describir el comportamiento de las partículas subatómicas, un nuevo conjunto de leyes es desarrollado por Max Planck, Albert Einstein, Werner Heisenberg y Erwin Schrödinger. Un salto cuántico se define como el cambio de un electrón en un átomo de un estado energético a otro.
-
El biólogo austríaco Karl Landsteiner y su grupo descubren cuatro grupos sanguíneos y desarrollan un sistema de clasificación.
-
William H. Bayliss y Ernest H. Starling les ponen este nombre y revelan su función como mensajeras químicas.
-
La energía es igual a masa por la velocidad de la luz al cuadrado, la famosa fórmula de Albert Einstein demuestra que la masa y la energía son manifestaciones distintas de una misma cosa, y que una cantidad muy pequeña de masa puede convertirse en una gran cantidad de energía.
-
Richard Oldham determina que las ondas sísmicas se mueven a través de la parte central de la Tierra. Sugiere que la Tierra tiene un núcleo líquido.
-
Bernard Brunhes descubre que el campo magnético de la Tierra ha cambiado de dirección y se invirtió gracias a su estudio de paleomagnetismo.
-
Thomas Hunt Morgan descubre que los genes se encuentran en los cromosomas. Llegó a la conclusión de que ciertos rasgos (cromosomas sexuales) están relacionados con el género y hace un mapa con las ubicaciones de los genes en los cromosomas.
-
Alfred Wegener propone que todos los continentes una vez formaron una sola masa de tierra; la evidencia consiste en la distribución de fósiles y similitudes geológicas.
-
El descubrimiento de que algunos materiales tienen la resistencia al flujo de electricidad promete revolucionar la tecnología; ocurre en una amplia variedad de materiales.
-
Niels Bohr publica su modelo de estructura atómica en la que los electrones viajan en órbitas alrededor del núcleo y las propiedades químicas de un elemento dependen del número de electrones. Esto ayuda para la comprensión de cómo los electrones están involucrados en los enlaces químicos.
-
Es una teoría del campo gravitatorio y de los sistemas de referencia generales, publicada por Albert Einstein.
-
Alexander Fleming descubre la penicilina que viene por accidente cuando se da cuenta de que el moho ha matado a una muestra de bacterias.
-
Frederick Banting y sus colegas descubren la hormona insulina, que ayuda a equilibrar los niveles de azúcar en la sangre en pacientes diabéticos y les permite llevar una vida normal.
-
Edwin Hubble determina la distancia de muchas galaxias cercanas y descubre que cuanto más lejos están, más rápido se están alejando de nosotros. Sus cálculos demuestran que el universo se está expandiendo.
-
Es su esfera central, está formado principalmente por hierro y níquel, tiene un radio de 3.486 km, consta de núcleo externo líquido, y núcleo interno sólido.
-
James Chadwick descubrió los neutrones, lo que cambió el modelo atómico y aceleró los descubrimientos en la física atómica.
-
Hans Krebs identifica los pasos que la célula necesita para convertir los alimentos en energía.
-
James Watson y Francis Crick describen la molécula de ADN, sugieren que está formada por dos cadenas de nucleótidos cada uno en una hélice.
-
Marshall Nirenberg dirige el equipo que descubre el código genético, mostrando que una secuencia de tres bases de nucleótidos (un codón) determina cada uno de los 20 aminoácidos.
-
El trabajo de muchos científicos revelan que la superficie de la Tierra está dividida en varias placas interconectadas. La capa más externa de la Tierra, la litosfera, está dividida en al menos siete piezas de gran tamaño, estas placas se mueven en diferentes direcciones y a diferentes velocidades.
-
Un número de científicos descubre el ácido ribonucleico o ARN, una sustancia química presente en el núcleo y el citoplasma de las células con una estructura similar al ADN.
-
Murray Gell-Mann propone la existencia de partículas fundamentales que se combinan para formar protones y neutrones, cada uno de ellos contienen tres quarks.
-
Arno Penzias y Robert Wilson descubrieron la radiación cósmica de microondas. Sus medidas, combinadas con las de Edwin Hubble se utilizan para demostrar que las galaxias están alejándose, lo que confirma la teoría del Big Bang.
-
Son explosiones de fotones de rayos gamma, son la forma más energética de luz y se relacionan con las explosiones nucleares, algunas se vinculan con la supernova (explosión que marca la muerte de estrellas).
-
Donald Johanson descubre el esqueleto parcial de un homínido hembra de 3,2 millones de años en Etiopía. Nombra a su descubrimiento como "Lucy", inspirado en la canción de los Beatles "Lucy in The Sky With Diamonds".
-
Harold Varmus y Michael Bishop descubrieron los oncogenes (controlan el crecimiento), pueden contribuir a la no conversión de células normales en células cancerosas (se multiplican sin control).
-
Bob Ballard y tripulación del sumergible Alvin encontraron formas de vida que viven independientes de la energía del sol en las profundidades marinas, a las que llamaron fuentes hidrotermales (géiseres submarinos volcánicos).
-
Las naves Voyager estudiaron y fotografiaron el sistema de Júpiter en 1979. En 1996 se puso en marcha un proyecto que permitiría observar Júpiter y sus lunas, al proyecto se le llamó Galileo.
-
Walter Alvarez postula que los niveles elevados de iridio encontrado en las muestras de roca de todo el mundo proporcionan pruebas de que un impacto de asteroide causó la extinción de los dinosaurios.
-
Los científicos Robert Gallo y Luc Montagnier, descubren un virus más tarde llamado VIH (virus de inmunodeficiencia humana) y es el causante del sida (síndrome de inmunodeficiencia adquirida).
-
En el marco de la relatividad general, y la predicción teórica de que los agujeros negros emitirían radiación (radiación de Hawking).
-
Astrónomos encuentran que en lugar de disminuir, debido a la atracción de la gravedad, la expansión del universo se está acelerando.
-
Tras la secuenciación del genoma humano, se descubre que los humanos tienen aproximadamente entre 20.000 y 25.000 genes.
Want to make a timeline like this?
Use Timetoast to turn dates, events, milestones, and phases into a clear visual timeline you can build and share. Timetoast is a timeline maker for work, school, research, and stories.